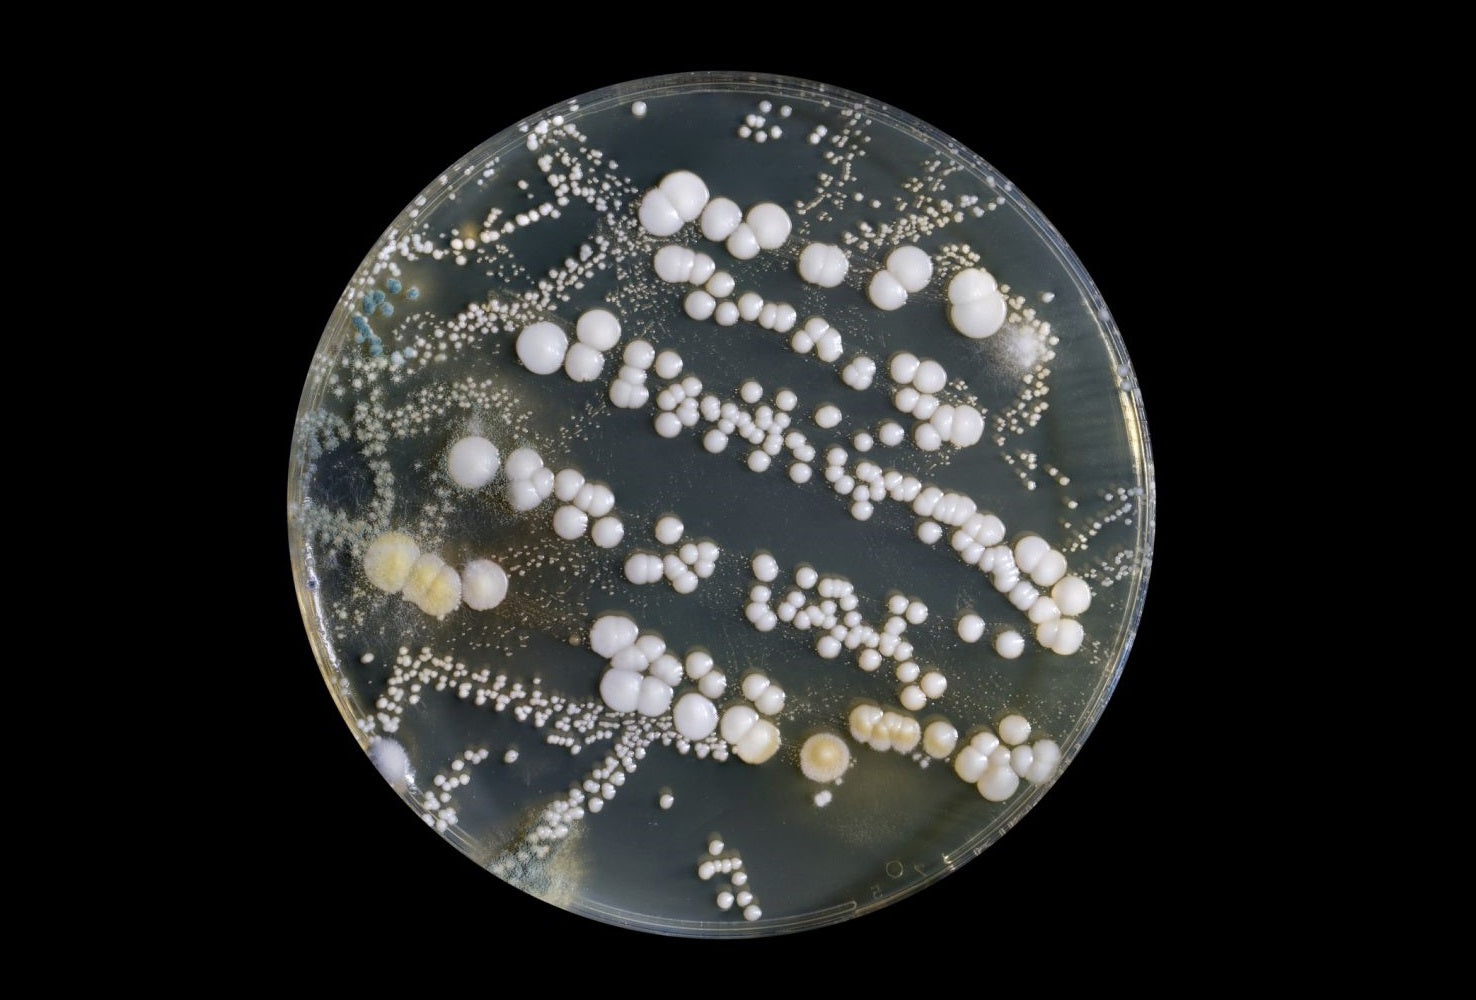

Alpha-lipoic acid
What is alpha-lipoic acid?
Alpha-lipoic acid (ALA) is a powerful antioxidant that plays a crucial role in energy production and the protection of cells from oxidative stress. It is unique because it is both water and fat soluble, allowing it to work in all parts of the body, unlike many other antioxidants that function only in specific environments. ALA helps convert glucose into energy by supporting mitochondrial function, making it vital for maintaining metabolic health and energy production. Additionally, its antioxidant properties help neutralize free radicals, reducing cell damage and promoting overall health. This makes ALA beneficial for a wide range of conditions, from improving skin health to supporting heart and liver function.
Key benefits
One of the key benefits of alpha-lipoic acid is its ability to help regulate blood sugar levels. It enhances insulin sensitivity and facilitates the uptake of glucose into cells, which can be particularly beneficial for individuals with type 2 diabetes or those at risk of insulin resistance. Studies (SYDNEY, SYDNEY-2, ALADIN, NATHAN-1, NATHAN-2, conducted by the German pharmaceutical company Asta Medica (now called Viatris)) have shown that ALA can help reduce symptoms of diabetic neuropathy, such as pain, burning, and numbness, by improving blood flow to nerves and reducing oxidative stress.
Effect on other antioxidants
ALA also has a regenerative effect on other antioxidants like vitamins C and E, as well as glutathione, which further amplifies its antioxidant impact in the body. By recycling these antioxidants, ALA helps protect cells from damage over time, potentially slowing the aging process and reducing the risk of chronic diseases like cardiovascular disease and neurodegenerative disorders.
Why we use the superior form of ALA: R(+)-Alpha-Lipoic Acid
There are two forms of alpha-lipoic acid: R(+)-alpha-lipoic acid and S(-)-alpha-lipoic acid, with R(+)-alpha-lipoic acid (R-ALA) being the naturally occurring form produced by the body. It is the most bioactive form, meaning it is more easily absorbed and utilized by cells. R-ALA is often considered superior to S-ALA in terms of potency and effectiveness, especially for therapeutic use. In contrast, S(-)-alpha-lipoic acid (S-ALA) is a synthetic version created during the production of alpha-lipoic acid supplements.
When both forms are combined in supplements, they are often referred to as rac-ALA or just alpha-lipoic acid, which includes both the natural (R) and synthetic (S) isomers. However, supplements that contain pure R(+)-alpha-lipoic acid are generally preferred due to their higher bioavailability and greater antioxidant potency. The rac-ALA version of alpha-lipoic acid is not as effective because the S type can cancel out some of the beneficial effects of the R type, reducing the overall efficacy of the supplement.
Conclusion
In summary, alpha-lipoic acid is a versatile antioxidant with benefits that include improved energy metabolism, enhanced insulin sensitivity, protection against oxidative stress, and support for other antioxidants. The natural R-alpha-lipoic acid form is more effective and better absorbed than its synthetic counterpart, making it a superior choice for those looking to maximize its health benefits.